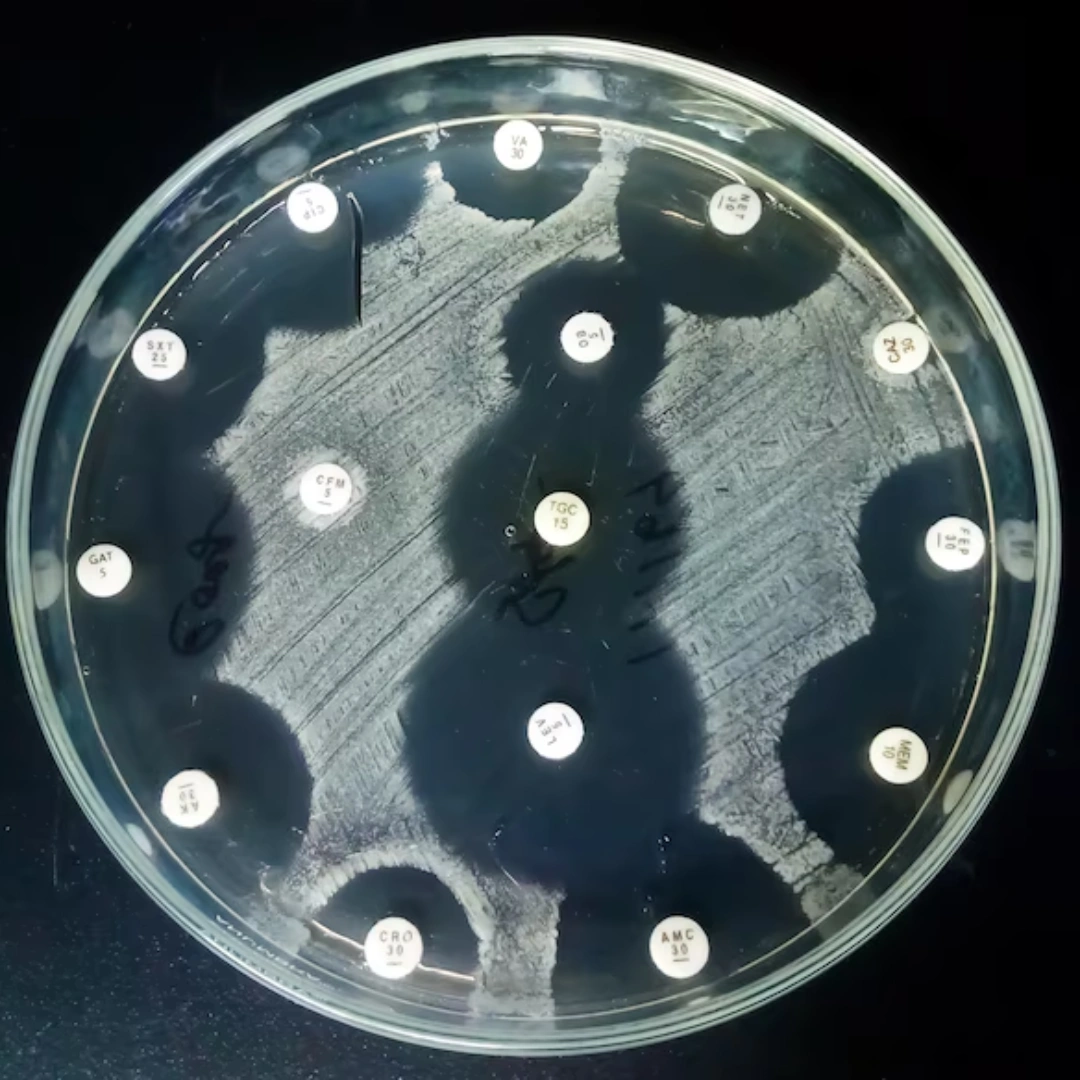
CULTURE, AEROBIC & SUSCE- PTIBILITY, MISCELLANEOUS

Culture, Aerobic & Susceptibility, Miscellaneous
What it is
The Culture, Aerobic & Susceptibility, Miscellaneous test is a microbiological study performed on various types of clinical specimens (such as wound swabs, pus, body fluids, or tissue samples) to detect aerobic bacteria—organisms that grow in the presence of oxygen. After isolating the bacteria, susceptibility testing is performed to determine which antibiotics are most effective against the identified pathogen.
Uses
This test is used to diagnose infections in sites not covered by standard urine, blood, stool, or sputum cultures. It is especially valuable in identifying localized or unusual infections involving wounds, abscesses, surgical sites, catheters, prosthetic devices, or other body fluids. The susceptibility profile guides doctors in prescribing targeted antibiotics, improving treatment outcomes and reducing antibiotic resistance.
Symptoms That May Lead to the Test
Doctors may order this test if you have unexplained fever, pus discharge, redness, swelling, pain at an infection site, non-healing wounds, or post-surgical infections. It is also commonly recommended in immunocompromised patients or those with indwelling medical devices such as catheters or implants.
Abnormal Results
Positive Culture: Indicates the presence of pathogenic aerobic bacteria in the sample. The susceptibility profile shows which antibiotics can effectively treat the infection.
Negative Culture: Suggests no growth of aerobic bacteria. This may point to viral, fungal, or anaerobic causes of infection, or sampling/handling issues.
Risks
The risks depend on the type of specimen collected. For superficial samples (like wound swabs), risks are minimal. For invasive procedures (such as aspirating pus or fluid), there may be mild discomfort, bruising, or rarely, bleeding or infection at the collection site. Proper sterile technique minimizes these risks.

Reviews
There are no reviews yet.